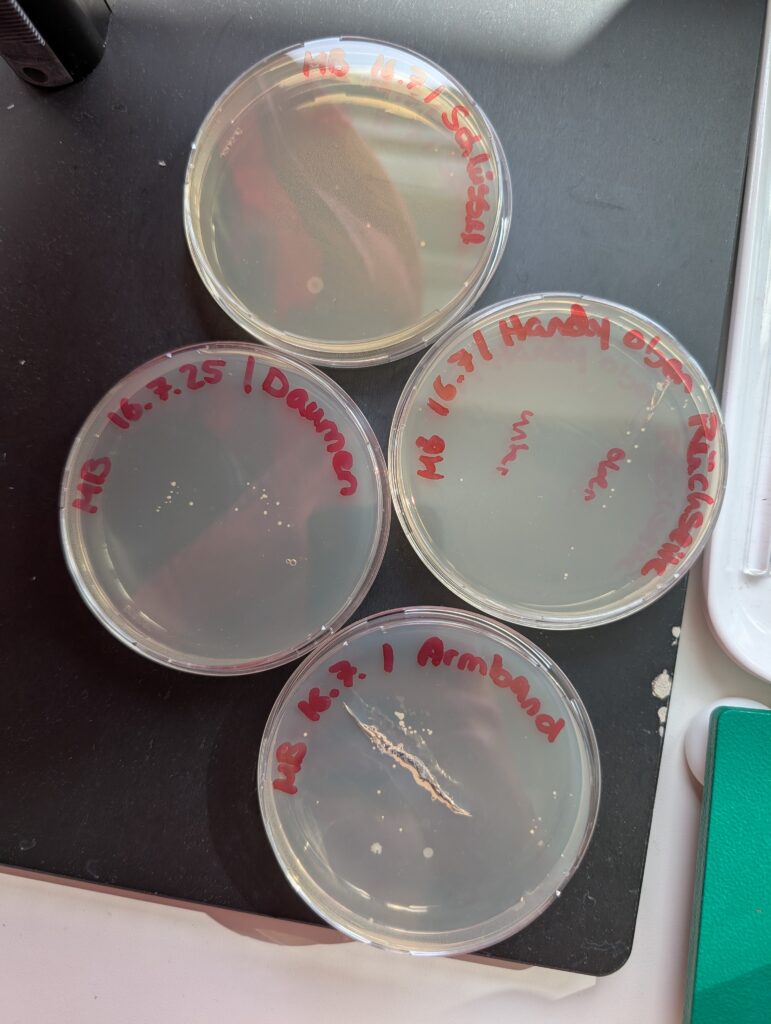

Zwei Wochen am Forschungszentrum Jülich – Einblicke in die Neurowissenschaft und darüber hinaus
von Thu Anh Nguyet Nguyen und Merle Emily Böker
Im Zeitraum vom 7. bis 18. Juli 2025 absolvierten wir ein zweiwöchiges Praktikum im Institut für Neurowissenschaften und Medizin (INM-2) am Forschungszentrum Jülich. Ziel unseres Praktikums war es, einen praxisorientierten Einblick in die neurowissenschaftliche Forschung zu erhalten sowie Methoden kennenzulernen, die für das Verständnis von Struktur und Funktion des Gehirns essenziell sind.
Während unseres Aufenthalts wurden wir von verschiedenen WissenschaftlerInnen begleitet, die uns ihre jeweiligen Arbeitsbereiche praxisnah vermittelten. Der folgende Bericht dokumentiert die einzelnen Stationen unseres Praktikums und erläutert die eingesetzten Methoden und ihre wissenschaftliche Bedeutung.
Am ersten Tag wurden wir von unserer Betreuerin im INM-2 begrüßt. Nach einer kurzen Führung durch das Institut und einer Vorstellungsrunde mit den Mitarbeitenden erhielten wir eine umfassende Sicherheitsunterweisung bezüglich des Arbeitens im Labor – insbesondere in Hinblick auf den Umgang mit Kryostaten, Färbemitteln und mikroskopischer Technik. (Diese Einweisung war notwendig, um versicherungstechnisch und sicherheitstechnisch korrekt im Labor arbeiten zu dürfen.)
Am Dienstag wurden wir mit dem Arbeiten am Kryostaten vertraut gemacht. Dabei handelt es sich um ein spezielles Schneideinstrument, das Hirnpräparate von Ratte und Maus, welche zuvor bei ca. -80°C gelagert worden waren, bei knapp -15°C in etwa 10–30µm dünne Schnitte zerschneidet. Diese Schnitte wurden auf beschichteten Objektträgern platziert, um ein Verrutschen der Präparate zu verhindern.
Wir durften diese Arbeit selbstständig durchführen und fertigten jeder etwa 20 Hirnschnitte an. Diese Präparate sollten im weiteren Verlauf des Praktikums eingefärbt und mikroskopisch untersucht werden.
Am folgenden Tag erfolgte die Kresylviolett-Färbung unserer Hirnschnitte. Diese Methode ermöglicht die Färbung von Neuronen mittels Kresylviolett-Acetat, ein basischer Oxazinfarbstoff, welcher die Zellkerne und die Nissl-Substanz violett, Nervenzellen schwach blau und andere Gewebesbestandteile gar nicht färbt. Während eine von uns färbte, mikroskopierte die andere Lichtmikroskop-Präparate von Maus-, Ratten- und menschlichem Hirngewebe.
Dass menschliche Gehirne ebenso individuell sind wie Fingerabdrücke erklärte uns ein erfahrener Biologielaborant. Lebensgewohnheiten, Interessen und kognitive Anforderungen führen zu messbaren Unterschieden in der Größe und Ausprägung bestimmter Hirnareale – ein Ausdruck der sogenannten neuronalen Plastizität.
Am Donnerstag trafen wir einen Physiker, der uns in die Funktionsweise und Anwendung des Magnetresonanztomographen (MRT) einführte. MRTs ermöglichen es, ohne operativen Eingriff die innere Struktur des Gehirns sichtbar zu machen, ob mit Fokus auf Blutgefäße, weichem oder harten Gewebe.
Er erläuterte auch funktionelle MRTs (fMRTs), die sowohl die Hirnaktivität unter bestimmten Denkaufgaben (wie beispielsweise dem Merken und Wiedergeben von Wörtern oder Zahlen) messen, wobei die Art jener Aufgaben entsprechend an das Ziel der Untersuchung angepasst wird, als auch für spezialisierte Verfahren wie die 31Phosphor-MRT verwendet werden, mit der zelluläre Energiestoffwechselprozesse dargestellt werden können. In seiner bahnbrechendsten Studie wurde zum Beispiel gezeigt, dass eine Kreatingabe kognitive Leistungssteigerungen bei physischer Erschöpfung (wie z.B. Schlafmangel) bewirkt – eine Erkenntnis, die neue Forschungsansätze im Bereich Neuroernährung und Leistungsphysiologie eröffnet.
Am Freitag erhielten wir spontan die Möglichkeit, eine Exkursion in das Institut für Biologie und Geowissenschaften (IBG-2) zu machen. Obwohl unser Praktikum im INM-2 stattfand, nutzten wir die Gelegenheit, einen Blick über den disziplinären Tellerrand hinaus zu werfen. Ein engagierter Biologielaborant führte uns durch verschiedene Gewächshäuser und Labore.
Forschende beschäftigen sich dort mit dem Verhalten von Nutzpflanzen unter Stressbedingungen, etwa Trockenstress oder nährstoffarmen Böden. Ihr Ziel ist es, klimaresiliente Pflanzensorten zu identifizieren, die auch unter sich wandelnden Umweltbedingungen hohe Erträge liefern. Wir erhielten Einblicke in Versuche, bei denen Pflanzen mit
zunehmenden Nährstoffgehalten sowie demineralisiertem Wasser unter kontrollierten Bedingungen kultiviert werden.
Abschließend durften wir beim Gießen verschiedester Pflanzen mithelfen und jeweils eine der Buchweizenpflanzen mit nach Hause nehmen, die zusätzlich zur benötigten Menge angepflanzt worden waren, um trotz misslingender Anzuchten ausreichend Pflanzen zur Verfügung stehen zu haben.
Der folgende Montag stand ganz im Zeichen der Elektronenmikroskopie, einer Methode zur Abbildung eines Objektes in sehr hoher Auflösung, sodass sogar die DNA oder Wassermoleküle klar erkennbar werden. Gemeinsam mit einer weiteren Biologielaborantin bereiteten wir Proben vor, welche uns Schülerinnen beispielhaft als für die Forschung relevante Proben dienten: Dazu wurde ein Gewebestück in Resin (Kunstharz) eingebettet und zu einem kleinen Block geformt. Dieser wurde in einem Ultramicrotom mithilfe eines Diamantmessers geschnitten – es entstehen sogenannte Ultradünnschnitte, etwa 60–100nm dick.
Diese Präparate ermöglichen eine strukturelle Auflösung im Nanometerbereich und dienen der Erstellung von 3D-Modellen von Neuronen, die mithilfe digitaler Bildrekonstruktion aus aufeinandergelegten Bildern entstehen. Diese Technik wird verwendet, um zum Beispiel den Aufbau von Mitochondrien detailliert zu modellieren.
Im Rahmen eines Projekts der aktuellen Forschung durften wir uns mit einer alternativen Methode der 3D-Rekonstruktion beschäftigen: Nach dem selektiven Einfärben einzelner Neuronen nach der Golgi-Methode (Silberfärbung) und dem Waschen der Hirnschnitte zur Entfernung überschüssiger Farbreste wurden diese digital nachgezeichnet – zum Teil mit Hilfe eines Virtual-Reality-Systems und entsprechenden Controllern — sodass die Verästelungen der Dendriten haargenau abgebildet wurden.
Da die Waschvorgänge in regelmäßigen Abständen gemacht werden müssen, nutzen wir die Wartezeiten am Dienstag, um die DNA einer Banane zu extrahieren (als schleimige Schicht mit vielen Luftbläschen erkennbar) und am Mittwoch, indem wir Bakterienkulturen mit Bakterien von Alltagsgegenständen auf einem Nährboden.
Am Folgetag konnten wir das Wachstum der Bakterienkolonien beobachten – ein anschaulicher Beweis für mikrobielle Vielfalt im Alltag.
Eine Bachelorstudentin stellte zum Abschluss ihrer Tätigkeit im Institut ihre Forschung zur Aktivität des glymphatischen Systems im Gehirn vor, mit welchem sich die Arbeitsgruppe des INM-2 beschäftigt. Dieses System ist maßgeblich an der nächtlichen „Reinigung“ des neuronalen Milieus beteiligt. Dabei leiten sogenannte Aquaporin-4-Kanäle Flüssigkeiten samt Schadstoffen aus dem neuronalen Gewebe in den paravaskulären Raum, von wo aus sie ins Blut abgegeben werden können.
Anschließend erhielten wir eine Führung durch das Tierhaus, in dem Labormäuse und -ratten unter professionellen tierpflegerischen Bedingungen gehalten und versorgt werden. Diese Tiere liefern unter anderem essenzielle Erkenntnisse über neuronale Krankheiten, an denen auch viele Menschen leiden.
Am letzten Tag bekamen wir die Möglichkeit, eine Ratte zu sezieren, um die Anatomie des Tieres und insbesondere das Lageverhältnis der Organe kennenzulernen. Danach erledigten wir letzte organisatorische Aufgaben zur Praktikumsdokumentation, bevor wir uns verabschiedeten und uns auf den Weg zurück nach Aurich machten.
Unser Praktikum ermöglichte uns vielfältige Einblicke in die Methoden und Abläufe neurowissenschaftlicher Forschung. Dabei lernten wir, dass Forschung viel Zeit, Geduld und ein gutes Maß an Frustrationstoleranz erfordert. Häufig bestehen Forschungstage aus langen Wartezeiten, dem Anfertigen von Protokollen und wiederholten Versuchsansätzen – bei gleichzeitig hoher fachlicher Präzision.
Die authentischen Eindrücke aus Labor, Mikroskopie-Raum, Gewächshaus und Computermodellierung erweiterten unser Wissen weit über schulische Inhalte hinaus.
Wir bedanken uns herzlich bei allen Beteiligten am INM-2 sowie am IBG-2 für ihre Offenheit, Geduld und die spannenden Einblicke im Rahmen unseres Schülerpraktikums.
veröffentlicht von: Mara Otten